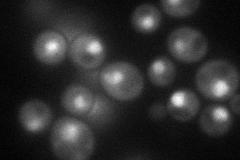
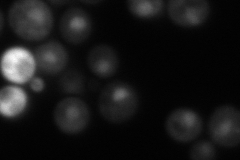
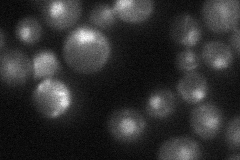

View description
Zinc cluster protein that is a master regulator involved in recruiting other zinc cluster proteins to pleiotropic drug response elements (PDREs) to fine tune the regulation of multidrug resistance genes
Localization:
Intensity:
Fold change:
Significance:
-
C’ GFP library in SD

nucleus23.53 -
N' NOP1pr-GFP in SD
nucleus61.9305 -
N' TEF2pr-mCherry in SD
nucleus79.49 -
N' NATIVEpr-GFP in SD
nucleus36.5766 -
N' TEF2pr-VC and Cyto-VN in SD

nucleus33.8439 -
C’ GFP library in SD+DTT

nucleus20.160.85No -
C’ GFP library in SD+H2O2

nucleus29.751.26No -
C’ GFP library in Starvation Media

nucleus29.291.24No -
C’ GFP library on the background of Pup2-DaMP

N/A -
C’ GFP library on the background of CCT mutant

N/A0N/AYes
